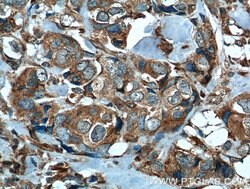
P4HA1 Mouse anti-Human, Mouse, Rat, Clone: 1H10A6, Proteintech 150 &mu;L;

missing translation for 'onlineSavingsMsg'
Learn More
Learn More
P4HA1 Mouse anti-Human, Mouse, Rat, Clone: 1H10A6, Proteintech
Mouse Monoclonal Antibody
Brand: Proteintech 66101-1-IG-150UL
This item is not returnable.
View return policy
Description
This antibody is specific to P4HA1.
This gene encodes a component of prolyl 4-hydroxylase, a key enzyme in collagen synthesis composed of two identical alpha subunits and two beta subunits. The encoded protein is one of several different types of alpha subunits and provides the major part of the catalytic site of the active enzyme. In collagen and related proteins, prolyl 4-hydroxylase catalyzes the formation of 4-hydroxyproline that is essential to the proper three-dimensional folding of newly synthesized procollagen chains. Alternatively spliced transcript variants encoding different isoforms have been described.Specifications
| P4HA1 | |
| Monoclonal | |
| 1 mg/mL | |
| PBS with 50% glycerol and 0.02% sodium azide; pH 7.3 | |
| P13674, P54001, Q60715 | |
| P4ha1 | |
| P4HA1 Fusion Protein Ag17867 | |
| 150 μL | |
| Primary | |
| Human, Mouse, Rat | |
| Antibody | |
| IgG1 |
| Immunocytochemistry, Immunofluorescence, Immunohistochemistry (Paraffin), Western Blot | |
| 1H10A6 | |
| Unconjugated | |
| P4HA1 | |
| 4 PH alpha 1, P4HA, P4HA1 | |
| Mouse | |
| Protein G | |
| RUO | |
| 18451, 5033, 64475 | |
| -20°C | |
| Liquid |
Product Content Correction
Your input is important to us. Please complete this form to provide feedback related to the content on this product.
Product Title
Spot an opportunity for improvement?Share a Content Correction